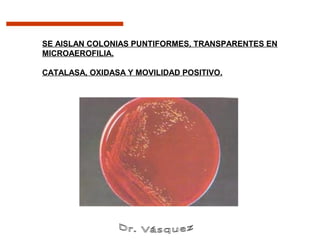
SE AISLAN COLONIAS PUNTIFORMES, TRANSPARENTES EN
MICROAEROFILIA.

CATALASA, OXIDASA Y MOVILIDAD POSITIVO.
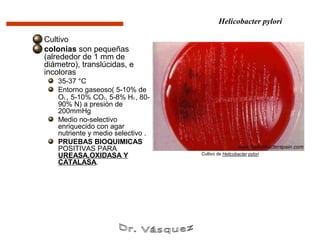
Helicobacter pylori

Cultivo
colonias son pequeñas
(alrededor de 1 mm de
diámetro), translúcidas, e
incoloras
    35-37 °C
    Entorno gaseoso( 5-10% de
    O2 , 5-10% CO2, 5-8% H2 , 80-
    90% N) a presión de
    200mmHg
    Medio no-selectivo
    enriquecido con agar
    nutriente y medio selectivo .
    PRUEBAS BIOQUIMICAS
    POSITIVAS PARA
    UREASA,OXIDASA Y                Cultivo de Helicobacter pylori
    CATALASA.

Campylobacter jejuni es una bacteria que causa diarrea y se transmite principalmente a través de alimentos o agua contaminados. Helicobacter pylori es una bacteria que infecta el estómago y puede causar úlceras gástrica y duodenal, así como cáncer gástrico. Ambas bacterias son transmitidas oralmente y colonizan el tracto gastrointestinal, causando inflamación y síntomas como diarrea y dolor abdominal.